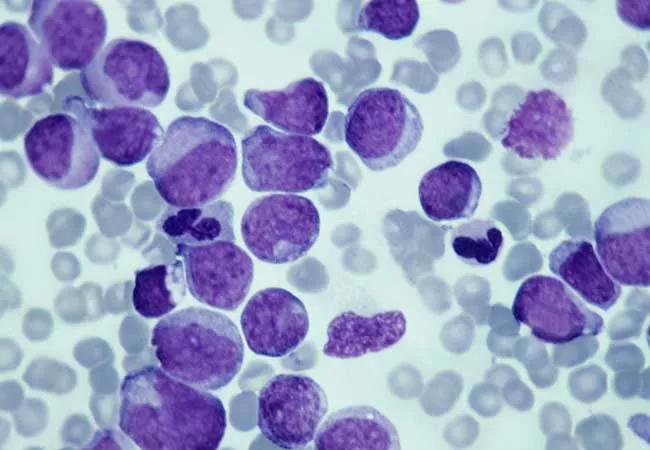

Retrospective study yields clues to understanding risk of secondary myeloid neoplasms
Image content: This image is available to view online.
View image online (https://assets.clevelandclinic.org/transform/b0af0b9c-d5fe-40bc-b26b-bd29b9121f90/22-CNR-3245747-CQD-Hero-650x450-aplastic-anemia_jpg)
22-CNR-3245747-CQD-Hero-650×450 aplastic anemia
This article has been excerpted and reprinted from the Journal of Clinical Oncology.
Advertisement
Cleveland Clinic is a non-profit academic medical center. Advertising on our site helps support our mission. We do not endorse non-Cleveland Clinic products or services. Policy
The risk of secondary myeloid neoplasms in patients with aplastic anemia is associated with disease severity, lack of response to treatment, and patients’ age, according to new research. Jaroslaw P. Maciejewski, MD, PhD of the Cleveland Clinic Department of Translational Hematology and Oncology Research participated in the multinational study.
Secondary myeloid neoplasms remain the most serious long-term complications in patients with non-transplanted acquired aplastic anemia or paroxysmal nocturnal hemoglobinuria (PNH). However, sMNs lack specific predictors, dedicated surveillance measures, and early therapeutic interventions.
To understand how clinical, cytogenetic, and molecular characteristics influence the risk of sMN, the researchers studied a retrospective cohort of 1,008 patients with aplastic anemia anemia or PNH, with a median follow-up of 8.6 years.
Although none of the patients transplanted upfront (n = 117) developed clonal complications (either sMN or secondary PNH), the 10-year cumulative incidence of sMN in non-transplanted cases was 11.6%. In severe aplastic anemia, older age at presentation and lack of response to immunosuppressive therapy were independently associated with increased risk of sMN, while untreated patients had the highest risk among non-severe cases. The elapsed time from aplastic anemia to sMN was 4.5 years. sMN developed in 94 patients. The five-year overall survival reached 40%, and was independently associated with bone marrow blasts at sMN onset.
Advertisement
Myelodysplastic syndrome with high-risk phenotypes, del7/7q, and ASXL1, SETBP1, RUNX1, and RAS pathway gene mutations were the most frequent characteristics. Cross-sectional studies of clonal dynamics from baseline to evolution revealed that PIGA/human leukocyte antigen lesions decreased over time, being replaced by clones with myeloid hits. PIGA and BCOR/L1 mutation carriers had a lower risk of sMN progression, while myeloid driver lesions marked the group with a higher risk.
sMN presented high-risk morphological, cytogenetic, and molecular features. Cross-sectional analyses revealed an inversion in clonal dynamics: PIGA/human leukocyte antigen mutations, predominant at baseline, were replaced by myeloid drivers at transformation. Lack of response to non-transplant treatments, older age, and myeloid driver mutations at aplastic anemia/PNH onset conferred higher risk of progression.
The landscape of acquired somatic mutations is complex, not thoroughly understood, and should be considered with caution in medical management.
Patients with aplastic anemia or PNH need close, prolonged monitoring with marrow morphology and cytogenetics. Morphological progression to sMN or occurrence of monosomy 7 should prompt clinicians to consider transplantation in eligible patients. Clinicians should carefully interpret the molecular profile with morphological and cytogenetic data for therapeutic decisions.
The full-length article is available at the Journal of Clinical Oncology.
Advertisement
Advertisement
Pilot Study at Cleveland Clinic is Testing Feasibility and Biodistribution
First-of-its-kind research investigates the viability of standard screening to reduce the burden of late-stage cancer diagnoses
Global R&D efforts expanding first-line and relapse therapy options for patients
Study demonstrates ability to reduce patients’ reliance on phlebotomies to stabilize hematocrit levels
A case study on the value of access to novel therapies through clinical trials
Findings highlight an association between obesity and an increased incidence of moderate-severe disease
Cleveland Clinic Cancer Institute takes multi-faceted approach to increasing clinical trial access 23456
Key learnings from DESTINY trials